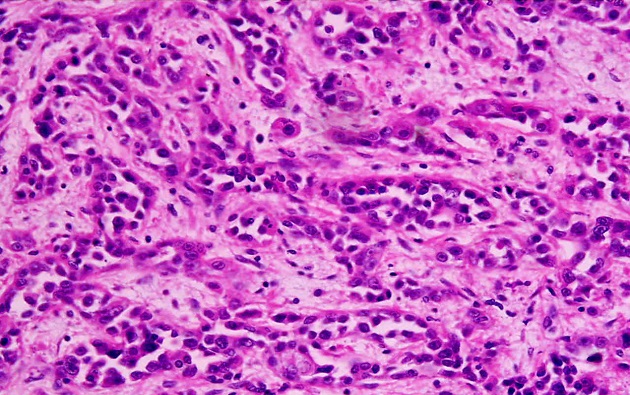

Une dépression sur deux n’est pas correctement diagnostiquée et traitée, aujourd’hui en France. Devant ce constat, l’Académie de médecine dénonce la méfiance dont font l’objet […]
La rédaction
LE CIEL DU MOIS DE JUIN
C’est en juin que les nuits sont les plus courtes dans l’hémisphère nord, et le ciel d’été, où commence à luire la Voie lactée, ses amas […]
MÉTÉO : QUE SE PASSE T-IL SUR JUPITER ?
C’est le phénomène météorologique le plus célèbre et le plus impressionnant de tout le système solaire : un anticyclone gigantesque, qui tourne inlassablement, là-bas, dans les nuages […]
A QUOI TIENT LA GROSSEUR D’UNE GOUTTE DE PLUIE ?
La taille d’une goutte d’eau dépend de la façon dont elle est formée et des différentes forces physiques qui vont s’appliquer sur elle. En altitude, les […]
POURQUOI LE CANCER TUE-T-IL DAVANTAGE LES PLUS DÉFAVORISÉS ?
Le Plan cancer, entre 2009 et 2013, a fait de la lutte contre les inégalités sociales face à la maladie l’une de ses priorités. Pourtant, […]
CANCER DU SEIN, LES VRAIS FACTEURS DE RISQUE
Toutes les femmes ne courent pas le même risque de développer un cancer du sein. Or, le dépistage est proposé à toutes après 50 ans, car l’âge […]
UNE ÉTRANGE EXOPLANÈTE DANS LA CONSTELLATION DES POISSONS
C’est un astre étrange que vient de découvrir une équipe internationale, essentiellement canadienne, dans la constellation des Poissons. Une exoplanète géante, GU Psc b, située à […]
QUE DEVIENT LE VIRUS DE LA GRIPPE EN ÉTÉ ?
C’est simple : il déménage sous des cieux plus favorables à sa propagation, c’est-à-dire froids et humides. « Le virus de la grippe est toujours quelque part […]
Un Prix international pour OTC à Paris le 21 Juin 2014
L’assurance qualité dans l’enseignement en ligne de OTC sera primé le 21 juin 2014 à Paris dans la catégorie Or par International Star for Leadership […]
POURQUOI L’EAU DU BAIN FUME ALORS QU’ELLE N’EST PAS À 100 °C ?
Il est vrai que l’on peut s’étonner de voir de la fumée au-dessus du bain ou même d’une casserole d’eau chaude, alors que c’est à 100 […]